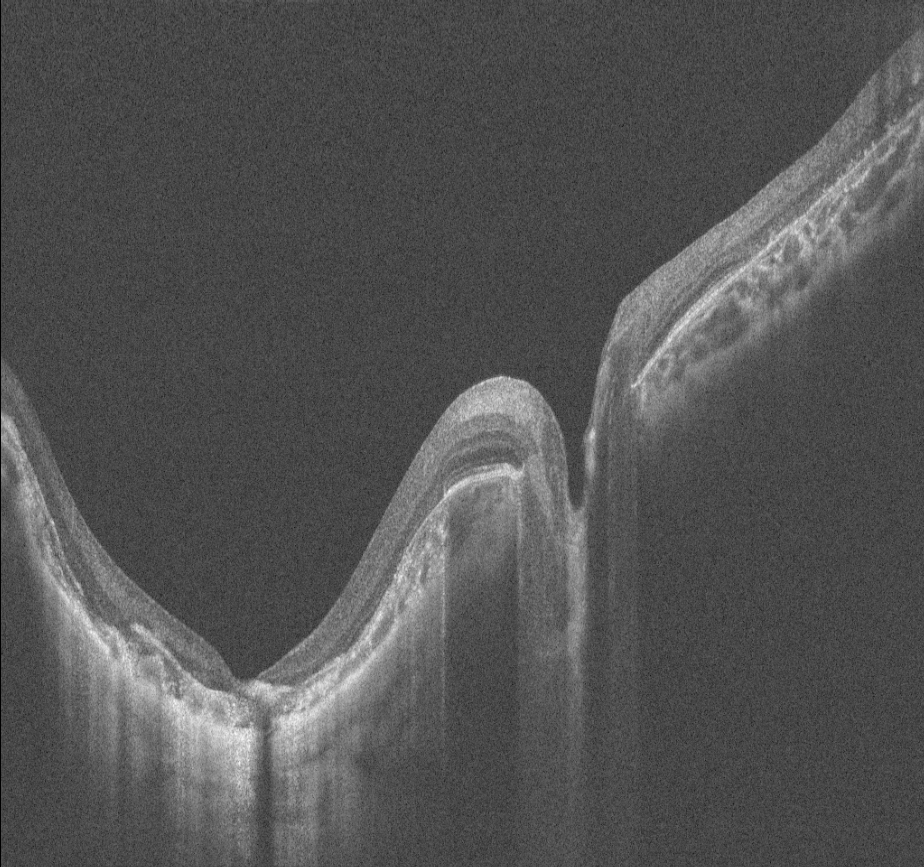

2026 Mayıs Ayın Sorusu
Okuma:14
14 yaşındaki erkek hasta bebeklikten bu yana görme kaybı öyküsü ile kliniğimize başvurmuştur. Ailenin tek çocuğudur, anne baba arasında akraba evliliği öyküsü mevcuttur ve her iki gözde görme 1 mps düzeyindedir. Hastanın renkli fundus, FAF ve OCT görüntülerini görmektesiniz. Lütfen cevabınızı aşağıya yazınız.
Ayın sorusunu bizimle paylaşan Dr. Mehmet ÇITIRIK’a katkıları için teşekkür ederiz.